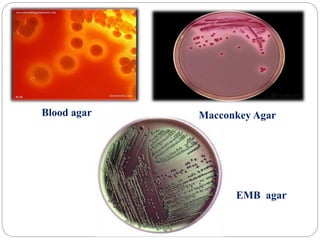
Blood agar Macconkey Agar
EMB agar

1. Enterobacteriaceae is a family of Gram-negative bacteria that includes many common pathogens. They are facultative anaerobes that are able to ferment glucose and reduce nitrates.
2. Escherichia coli is the most prominent member of Enterobacteriaceae. It is commonly found in the human gut but can cause diseases like diarrhea, urinary tract infections, and sepsis. Virulence factors include toxins, fimbriae, and capsular antigens.
3. Other important pathogens in Enterobacteriaceae include Salmonella, Shigella, Klebsiella, and Proteus, which can cause diseases like typhoid fever, dysentery, pneumonia, and